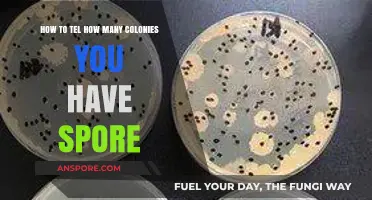
Counting Colonies in Spore: A Simple Guide to Tracking Your Empire

Taking a spore print from Penis Envy mushrooms is a crucial step for mycologists and cultivators looking to preserve or propagate this unique strain. To begin, ensure you have a mature, fully opened mushroom cap, as the spores are released from the gills underneath. Place the cap gills-down on a piece of aluminum foil or glass, and cover it with a bowl or container to create a humid, enclosed environment. After 6-12 hours, carefully remove the cap and inspect the surface for a fine, purplish-black spore deposit. This print can then be stored in a cool, dark place or used to inoculate substrate for cultivation. Proper sterilization and handling are essential to avoid contamination during the process.
| Characteristics | Values |
|---|---|
| Mushroom Species | Penis Envy (Panaeolus cyanescens or Psilocybe cubensis variant) |
| Spore Print Color | Dark purple to black |
| Tools Required | Glass or jar, aluminum foil, scalpel or knife, gloves, paper or foil |
| Timing | Best taken when the cap is fully open but before spores drop naturally |
| Environment | Clean, sterile area to avoid contamination |
| Process Steps | 1. Sterilize tools. 2. Place foil over glass. 3. Place mushroom cap gills down on foil. 4. Cover with jar/glass. 5. Wait 4-8 hours. 6. Remove and let dry. |
| Storage | Store in a cool, dark place in an airtight container |
| Shelf Life of Spores | Up to 2 years if stored properly |
| Legal Considerations | Spores are legal in many regions, but cultivation may be illegal |
| Contamination Risks | Bacteria, mold, or other fungi if not handled in a sterile environment |
| Alternative Methods | Using agar plates or spore syringes for more controlled collection |
| Difficulty Level | Moderate (requires precision and cleanliness) |
| Purpose | Research, microscopy, or cultivation (where legal) |
What You'll Learn
- Prepare sterile workspace and materials for spore printing to prevent contamination
- Select mature, fully developed Penis Envy mushroom caps for optimal spores
- Place glass over the cap, secure with foil, and wait 2-6 hours
- Carefully remove glass, ensuring spore print is intact and undisturbed
- Store spore print in a cool, dark place or use for inoculation

Prepare sterile workspace and materials for spore printing to prevent contamination
Contamination is the arch-nemesis of successful spore printing, capable of rendering your entire effort futile. Even a single stray bacterium or mold spore can outcompete your desired fungus, leading to inaccurate or unusable results. This makes sterilization not just a step, but the foundation of the entire process.
Every surface, tool, and container must be treated as a potential threat until proven otherwise.
Achieving a sterile environment begins with meticulous cleaning. Start by designating a workspace away from high-traffic areas and potential sources of airborne contaminants like open windows or pets. Wipe down all surfaces with a 70% isopropyl alcohol solution, paying particular attention to areas where spores might settle. This includes your workbench, any equipment you'll be using, and even your hands. Allow the alcohol to air dry completely; residual moisture can encourage bacterial growth.
For heat-resistant materials like glass slides, scalpels, and tweezers, autoclaving is the gold standard. This process utilizes steam under pressure to kill all microorganisms, including spores. If an autoclave isn't available, boiling these items for at least 20 minutes can provide a reasonable level of sterilization.
Not all materials can withstand autoclaving or boiling. For these, a combination of disinfection and careful handling is key. Use sterile, disposable gloves throughout the entire process to minimize the transfer of skin flora. Any containers or bags used for storing the mushroom or spore print should be pre-sterilized with alcohol or a dilute bleach solution (10% bleach, 90% water), followed by thorough rinsing and air drying. Remember, even the slightest oversight can introduce contaminants, so treat every step with the utmost care.
Even with the most stringent sterilization protocols, vigilance is paramount. Work quickly and efficiently to minimize the time your materials are exposed to the environment. Keep your workspace organized and clutter-free to reduce the risk of accidental contamination. If you notice any signs of mold or bacterial growth during the process, discard the affected materials and start anew. Remember, the goal is not just to collect spores, but to collect them in a way that ensures their purity and viability for future use.
British Colonial Rule and the Entrenchment of India's Caste System
You may want to see also

Select mature, fully developed Penis Envy mushroom caps for optimal spores
The success of a Penis Envy spore print hinges on the maturity of the mushroom caps you select. Immature caps lack the fully developed spore-bearing tissue, resulting in a weak or incomplete print. Look for caps that have fully expanded, with edges beginning to curl inward or upward. The veil—the thin membrane beneath the cap—should have torn, exposing the gills completely. This stage, typically reached 12-18 hours after the veil breaks, ensures maximum spore production.
Opting for younger caps, while tempting due to their pristine appearance, will yield disappointing results.
Selecting mature caps isn’t just about aesthetics; it’s a matter of spore viability. Fully developed Penis Envy mushrooms have had ample time to produce and mature their spores, ensuring a higher concentration and better germination rates for future cultivation. A mature cap’s gills will appear darker and more pronounced, a visual cue that the spores are ready for collection. Conversely, gills on immature caps may look pale or underdeveloped, indicating insufficient spore production. Patience in waiting for this stage is rewarded with a robust spore print.
To identify the ideal cap, examine the mushroom’s overall structure. The stem should be sturdy, and the cap should feel firm yet pliable, not spongy or soft. Avoid caps showing signs of decay, such as discoloration or a slimy texture, as these may harbor contaminants. A healthy, mature Penis Envy mushroom will have a distinct phallus-like shape, with the cap fully open and gills exposed. Use a magnifying glass to inspect the gills for spore maturity—they should appear powdery or slightly dusty, a sign that the spores are ready for collection.
Practical tips for selection include harvesting mushrooms in the late morning or early afternoon, when spore release is typically at its peak. Work in a clean environment to minimize contamination, and handle the mushrooms gently to avoid damaging the delicate gills. If you’re unsure about maturity, err on the side of waiting an extra day. Once you’ve identified the perfect cap, proceed with the spore print process immediately to capture the spores at their peak potency. This careful selection ensures a high-quality print, setting the foundation for successful cultivation.
Understanding How Black Mold Spores Enter and Spread in Homes
You may want to see also

Place glass over the cap, secure with foil, and wait 2-6 hours
The glass-and-foil method is a simple yet effective technique for capturing spores from a mushroom cap, particularly for species like Penis Envy. By placing a glass over the cap and securing it with foil, you create a contained environment that encourages spore release. This method leverages the natural process of spore dispersal, ensuring a clean and efficient collection. The waiting period of 2-6 hours allows sufficient time for spores to settle onto the glass surface, forming a detailed print that can be used for identification or cultivation.
Instructively, the process begins by selecting a mature mushroom with an open cap, ensuring the gills are fully exposed. Gently place a clean, dry glass or jar over the cap, taking care not to touch the gills. Secure the glass with aluminum foil, wrapping it tightly around the base to create an airtight seal. This setup prevents contamination and directs the spores downward onto the glass surface. Patience is key during the 2-6 hour waiting period, as rushing the process may result in an incomplete or uneven spore print.
Comparatively, this method stands out for its simplicity and reliability. Unlike other techniques that require specialized equipment or materials, the glass-and-foil method uses household items, making it accessible to beginners. It also minimizes the risk of contamination, a common issue with open-air spore collection methods. While it may take longer than using a spore syringe, the resulting print offers a visual record of the mushroom’s spore pattern, valuable for taxonomic studies or personal documentation.
Descriptively, the final spore print resembles a delicate, powdery design on the glass surface, often mirroring the gill pattern of the mushroom. This print can be carefully transferred to a dark surface or stored between slides for preservation. For practical use, ensure the glass is thoroughly cleaned and dried before starting, and handle the foil-wrapped setup gently to avoid disturbing the spores. With its balance of precision and ease, this method is a go-to for both hobbyists and mycologists seeking to capture the essence of a mushroom’s reproductive cycle.
Roses Reproduction: Seeds or Spores? Unveiling the Truth About Rose Propagation
You may want to see also

Carefully remove glass, ensuring spore print is intact and undisturbed
The delicate nature of spore prints demands precision when removing the glass covering. A single misstep can disrupt the intricate pattern, rendering the print unusable for cultivation or study. This critical step requires a steady hand and a mindful approach, ensuring the spores remain undisturbed.
Technique and Timing:
Begin by gently lifting the edge of the glass using a sterile tool, such as a scalpel or tweezers. Tilt the glass at a shallow angle, allowing it to slide smoothly away from the substrate. Avoid dragging or pressing down, as this can smear the spores. Optimal timing is crucial—wait until the veil has fully broken, but act before the spores begin to naturally disperse. For *Penis Envy* mushrooms, this typically occurs 12–24 hours after the cap opens, depending on humidity and temperature.
Environmental Considerations:
Maintain a controlled environment during this process. A still workspace minimizes air currents that could prematurely dislodge spores. Humidity levels should remain above 80% to keep the print surface moist but not waterlogged. If using a glove box or still air box, ensure it’s free of contaminants and equipped with a HEPA filter for sterile conditions.
Troubleshooting Common Mistakes:
If the glass adheres to the substrate, resist the urge to force it. Instead, introduce a small amount of sterile water or alcohol around the edges to loosen the seal. For stubborn cases, warm the glass slightly with a hairdryer set to low heat, but avoid overheating, as this can damage the spores. Always inspect the print under magnification post-removal to confirm its integrity.
Preservation and Storage:
Once the glass is removed, immediately secure the spore print with a sterile cover or transfer it to a slide for long-term storage. Label with the strain name (*Penis Envy*), date, and environmental conditions for future reference. Stored in a cool, dark place, a properly handled spore print can remain viable for up to two years, making this step a cornerstone of successful mycological practice.
Inoculating Grain with Spores: A Comprehensive Guide to the Process
You may want to see also

Store spore print in a cool, dark place or use for inoculation
Once you’ve successfully captured a Penis Envy spore print, proper storage is critical to preserve its viability. Spores are resilient but not invincible. Exposure to light, heat, and moisture can degrade their quality over time. A cool, dark place—like a sealed envelope stored in a drawer or a refrigerator—is ideal. Aim for temperatures between 35°F and 50°F (2°C to 10°C) to slow metabolic activity and extend shelf life. Avoid freezing, as ice crystals can damage spore cell walls. Darkness prevents UV radiation from breaking down genetic material, ensuring the spores remain potent for future use.
If immediate inoculation is your goal, act swiftly. Spores are most viable within the first few weeks after collection. Prepare your substrate—sterilized grain or agar—and use a sterile scalpel or needle to transfer spores directly. For liquid culture, suspend the spore print in distilled water with a gentle stir, then transfer to a sterile jar. Always work in a clean environment to prevent contamination. Proper technique here can mean the difference between a thriving mycelium network and a failed batch.
Comparing storage to immediate use highlights a trade-off between convenience and urgency. Stored prints offer flexibility for future projects but require meticulous care to maintain viability. Inoculation, on the other hand, demands immediate attention but yields faster results. For hobbyists, storing prints allows experimentation over time; for commercial growers, inoculation prioritizes efficiency. Choose based on your timeline and resources, but remember: stored spores are not immortal.
A practical tip for long-term storage is to use desiccant packets in the storage container to absorb excess moisture. Label each print with the date and strain to avoid confusion, especially if working with multiple varieties. For inoculation, practice sterile technique rigorously—flame-sterilize tools, work in front of a laminar flow hood if possible, and use gloves. Whether storing or inoculating, precision and attention to detail are non-negotiable in the world of mycology.
How Spores Vex Humans: Unseen Threats and Their Impact
You may want to see also
Frequently asked questions
A penis envy spore print is a method of collecting spores from a penis envy mushroom (a strain of Psilocybe cubensis) by placing the cap on a piece of foil or glass, allowing the spores to drop. It’s important for preserving genetics, cloning, or growing new mushrooms.
Ensure the mushroom is fully mature with open gills. Sterilize your workspace and tools to avoid contamination. Gather clean foil or glass, a scalpel or knife, and a container for storage.
1. Cut the stem of the mushroom, leaving the cap intact. 2. Place the cap gills-down on foil or glass. 3. Cover with a cup or container to create a humid environment. 4. Wait 24 hours for spores to drop. 5. Carefully remove the cap and store the print in a sealed container.
Place the spore print in a clean, dry, and airtight container, such as a glass vial or envelope. Store it in a cool, dark place to preserve viability. Label with the date and strain for future reference.